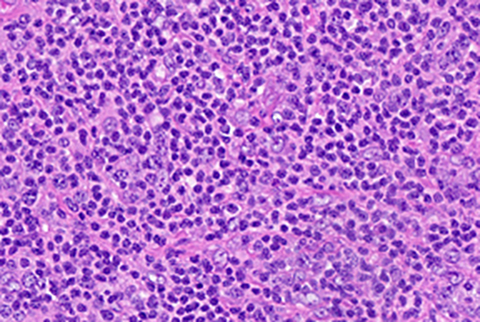

January 2021 Case
Clinical History
Middle aged male patient, otherwise healthy with only minor health issues, presented with progressive cervical lymphadenopathy. Imaging showed numerous enlarged lymph node throughout his neck, measuring up to 4.5 cm. He did not have any systemic B-symptoms. Further examination showed mild splenomegaly and mildly enlarged lymph nodes in the chest, abdomen, and pelvis. He had a fine needle aspiration performed which was inconclusive (atypical lymphoid hyperplasia).
His labs at initial consultation showed WBC of 16.24 x 10³/µL, Hgb 12.5 g/dL, and platelets 197 x 10⁶/µL. No differential was available, however the previous CBC demonstrated increased lymphocytes. Additionally, his labs showed a mild increase in AST and ALT, reaching up to 172 and 288 soon after his initial visit. A lymph node biopsy is performed, followed by a liver biopsy and a bone marrow biopsy.
Lymph node biopsy
H & E

CD20+ B-cells

CD4+ T-cells

CD30

PD1

TIA1

ALK
A diffuse proliferation of small-medium cells is seen with loss of nodal architecture. They are CD4+ T-cells with loss of CD5 and CD3 (partial). CD30 (variable), CD43, granzyme, TIA1, and ALK are positive; CD8, PD1, CXCL13, CD10, BCL6 and TCL1 are negative. The immunophenotype and features are consistent with small cell variant of anaplastic large cell lymphoma.
Discussion: Anaplastic Large Cell Lymphoma
Anaplastic large cell lymphoma (ALCL) is a T-cell lymphoma with systemic ALK positive and negative types among others. They have variable morphology, including several different histological patterns described in ALK+ ALCL. ALK positive cases typically affect younger patients and are associated with a better prognosis while ALK negative lymphomas affect older individuals with worse outcomes. The most common translocation for ALK+ cases is t(2;5) in approximately 80% of cases, however other fusion partners for ALK also exist on a number of other chromosomes. DUSP22 (6p25) and TP63 rearrangements may occur in ALK negative cases. Prognostically, positivity p63 conveys a worse prognosis while the presence of DUSP22 rearrangement is associated with a better outcome.
In the lymph node, the principal T-cell lymphoma differential diagnosis includes peripheral T-cell lymphoma NOS (PTCL-NOS) and angioimmunoblastic T-cell lymphoma (AITL). A key feature of ALCL's are pleomorphic, horseshoe-shaped "hallmark" cells which may be variable in size. The tumor cells are strongly CD30 positive (with large cells typically stronger than small cells), unlike the other entities previously mentioned. Additionally, ALCL expresses cytotoxic markers such as TIA-1 (unlike PTCL-NOS) but do not express follicular helper cell markers such as PD1 or have expanded/disrupted follicular dendritic cell networks (unlike AITL).
ALK+ ALCL can demonstrate several different histological patterns. The "classic" pattern is the most common (approximately 60% of cases) in which large pleomorphic cells predominate. Other less common patterns include lymphohistiocytic (10%), Hodgkin's like (3%), small cell (5-10%) or composite patterns. The case presented above is an example of small cell pattern. There is a diffuse proliferation of mostly small to medium cells, with some showing a moderate amount of pale cytoplasm. In this case, most cells are CD4 positive and a subset (medium and few large cells) strongly express CD30 and ALK. It is important to note that hallmark cells may be absent in the small cell variant of ALCL. Therefore, immunohistochemistry for ALK will be crucial as diagnosis will be challenging without ALK staining. The small cells may be weak or negative for CD30 (as we can see in a subset in the CD30 photomicrograph above). Together with the negative PD1 and positive cytotoxic markers, the immunophenotype in this case is consistent with ALK+ ALCL.
Another potential pitfall seen in subsequent cases from this patient is subtle sinusoidal involvement (illustrated below). Lymph node sinusoidal disease is recognized in ALCL and may be misdiagnosed as a carcinoma or other neoplasm. In this patient, there was a subtle population of small lymphocytes within the sinusoids of the liver (see images below). These consisted of a mixture of CD4 and CD8 T-cells, a subset of which expressed cytotoxic markers and CD30. A subset also expressed ALK, which is consistent with involvement by ALCL. A similar pattern of disease was also seen in the bone marrow, where focal small ALK+ T-cells were present which were otherwise not noticeable on routine H&E slides.
Liver biopsy

H&E high power

ALK
References
- Swerdlow, SH., Campo, E et al. WHO Classification of Tumours of Haematopoietic and Lymphoid Tissues (Revised 4th Edition). IARC: Lyon 2017
- Montes-Mojarro, IA., Steinhilber, J et. al. The Pathological Spectrum of Systemic Anaplastic Large Cell Lymphoma (ALCL). Cancers (Basel) 2018 Apr; 10(4): 107
- Hapgood, G., Savage, KJ. The biology and management of systemic anaplastic large cell lymphoma. Blood 2015; 126 (1): 17–25
- Pletneva, MA., Smith, LB. Anaplastic Large Cell Lymphoma: Features Presenting Diagnostic Challenges. Arch Pathol Lab Med 1 October 2014; 138 (10): 1290–1294